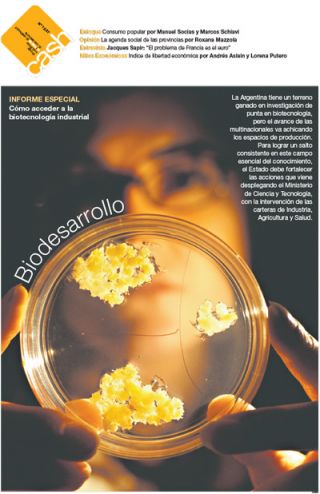

SUPLEMENTOS
Futuro
Sábado, 8 de febrero de 2014
Según el cristal que se mire
AÑO INTERNACIONAL DE LA CRISTALOGRAFÍA
Las Naciones Unidas declararon a 2014 como el Año Internacional de la Cristalografía.
En este número de Futuro nos ocupamos de una disciplina que, aunque no muy popular,
ha aportado al conocimiento profundo de sustancias que van desde los minerales a las proteínas. Y que, como si todo esto fuera poco, fue el terreno en el que se destacaron químicos, matemáticos, un obispo recientemente beatificado y uno de los pioneros de la Sociología de la Ciencia.
M2
Sábado, 8 de febrero de 2014
audiencias
el Caap tiene una maratón y marzo promete una cabalgata de leyes a debatir
Soy
Viernes, 7 de febrero de 2014
SOS MI VIDA
La Monita Esteche, campeona mundial de boxeo, le dedicó públicamente el título a su mujer. Pronto nadie se asombrará, ni para bien ni para mal.
Las12
Viernes, 7 de febrero de 2014
YO ABUSO
LO QUE EMERGE DE LA CARTA DONDE DYLAN FARROW DENUNCIA LOS ABUSOS SEXUALES DE SU PADRE, WOODY ALLEN
- BANANAS
- Sin un pan bajo el brazo
- La prevención del cáncer
- Amor correspondido
- La textura del tiempo
- Que vivan los triunfos
- El insomnio
- Diversidad y contraste
- Sensatez y sentimientos
- Con tetas tampoco hay paraíso
- ¿Qué es un hombre?
- La ciencia de ser mujer
- Sacar el aborto del closet
- La paria
- Lo que sangra
NO
Jueves, 6 de febrero de 2014
Las ruedas mágicas
De la ruta del Che, tal vez el primer motero latinoamericanista, a un viaje a Paysandú con un motoclub, el NO se sumerge en el ruido a motores, el aroma a grasa y nafta y el calor del cuero.
LIBERO
Lunes, 3 de febrero de 2014
PATINADA
El esfuerzo de Carlos Berlocq no fue suficiente para vencer al italiano Fabio Fognini, que lo derrotó en cuatro sets en el Patinódromo marplatense. De esa manera, el conjunto argentino deberá jugar el repechaje para mantener la categoría por primera vez desde que volvió al Grupo Mundial de la Copa Davis en 2001.
- El talento de Fognini pudo más que el esfuerzo de Berlocq
- El campeón hizo los deberes
- “Si se lo propone, Messi puede llegar a ser más que Maradona”
- El festejo fue para el Lobo
- No hicieron la pole position, pero largan en primera fila
- Un balance de fin de temporada
- Le dan la bienvenida
- Nada es seguro
- Los mira a todos desde arriba
- Se quedó con el clásico y con baile
- Insúa y el objetivo
- Vienen por Parra
- Con cuatro lesionados
- El estreno del Yacaré
- A embocar a los rivales
- La Doble Bragado
- Bicampeón en Coronda
- Goleadores argentinos
- Otra vez Arsenal
- Siguen las lesiones
Cash
Domingo, 2 de febrero de 2014
BIODESARROLLO
La Argentina tiene un terreno ganado en investigación de punta en biotecnología, pero el avance de las multinacionales va achicando los espacios de producción. Para lograr un salto consistente en este campo esencial del conocimiento, el Estado debe fortalecer las acciones que viene desplegando el Ministerio de Ciencia y Tecnología, con la intervención de las carteras de Industria, Agricultura y Salud.
Radar
Domingo, 2 de febrero de 2014
ARENA EN LOS ZAPATOS
Juan Sasturain presenta Dudoso Noriega, su novela marplatense, y un libro de conversaciones con Alberto Breccia
- MIENTRAS MIRO LAS NUEVAS OLAS
- EL FANTASMA DE LA LIBERTAD
- LA PELÍCULA DE MI VIDA
- A CUERPO DE REINA
- LA VIDA ENTRE LA MUERTE
- MÁS RESPETO QUE SOY TU MADRE
- LO FRÁGIL Y LO EFÍMERO
- EL SECRETO DE SUS OJOS
- GOLPE A GOLPE
- MIRAR PERO NO VIVIR
- SALIR DE LA BATICUEVA
- OJOS QUE VEN, Y DAN VUELTAS
- LA REUNIÓN CUMBRE QUE NUNCA FUE
- FUTURAMA
- Inevitables
- A COMER EN VERANO
- F.Mérides Truchas
Radar libros
Domingo, 2 de febrero de 2014
VIDA DE ESTE CHICO
En Informe del interior, Paul Auster plantea un viaje al mundo de su infancia para recuperar la perspectiva de un niño que el mundo adulto casi ha borrado, aun cuando reconoce ciertos vestigios todavía vigentes. La educación de un joven norteamericano de clase media, la vida en una ciudad mediana en los años cincuenta, la pasión por los deportes y la marca a fuego de ciertas películas constituyen los hitos de su vida como chico. También se reeditaron sus Ensayos Completos, un excepcional volumen que abarca libros enteros, artículos y entrevistas.
Turismo
Domingo, 2 de febrero de 2014
CARNAVAL EN GUALEGUAYCHÚ
Comparsas, desfiles, lentejuelas, música y bailes para festejar los ritos carnavalescos más grandes del país.
(Versión para móviles / versión de escritorio)
© 2000-2026 www.pagina12.com.ar | República Argentina
Versión para móviles / versión de escritorio | RSS ![]()
Política de privacidad | Todos los Derechos Reservados
Sitio desarrollado con software libre GNU/Linux